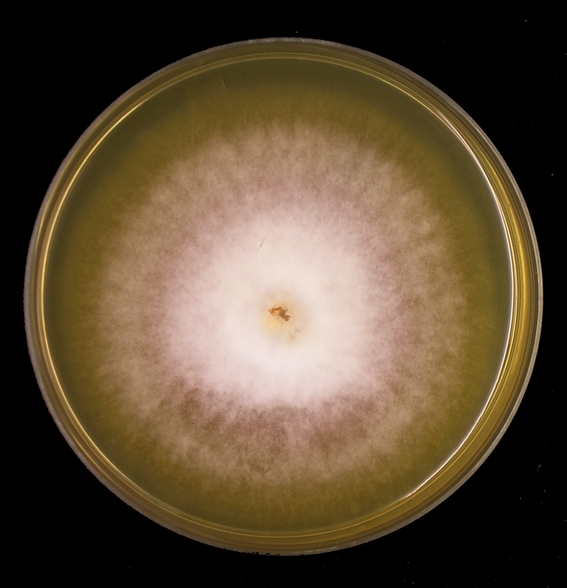

Microsporum canis на среде Сабуро: развитие и структура

Раздел: Природная галерея